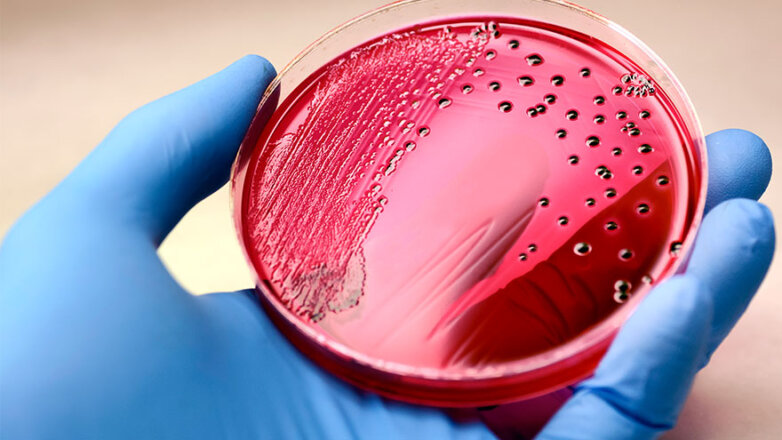
Συχνή η σήψη όσο ο καρκίνος

Συχνή η σήψη όσο ο καρκίνος
Στα σουηδικά νοσοκομεία, μόνο το 2% των ασθενών με σήψη είναι ανθεκτικοί στα αντιβιοτικά αλλά οι ερευνητές εικάζουν ότι το ποσοστό των ανθεκτικών περιπτώσεων είναι υψηλότερο σε πολλές άλλες ευρωπαϊκές χώρες.
25/09/2023 | 10:15